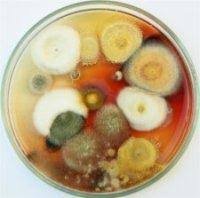

Por que o Laboratório Militello ?
O Laboratório Militello
possui uma unidade técnica que realiza exames microbiológicos, atendendo à pacientes internados que necessitam de resultados precisos e imediatos.
Cotamos com uma equipe altamente especializada, e fornecemos um banco de dados direcionado para cada equipe médica.
Fornecemos aos médicos responsáveis, o Relatório de Infecção Hospitalar, contendo os resultados de pacientes com culturas positivas e respectivos antibióticos liberados.
Além dos exames de microbiologia, realizamos exames de Análises Clínicas e Toxicológicos, de urgência.
Profissionais experientes
A equipe do Laboratório Militello
é formada somente por profissionais treinados e habilitados, seguindo normas técnicas rigorosas.
Controle de Qualidade
Participamos de Controles de Qualidade Interno e Externos, o que garante resultados rápidos e precisos.
Instalações Técnicas
Nossas instalações são planejadas de acordo com as rígidas normas técnicas da Vigilância Sanitária e demais orgãos competentes.
Base De Resultados
Realizamos exames com prazos definidos como urgentes, liberando resultados parciais para os médicos, enfermeiros ou diretamente ao paciente.
O Bando de Resultados são definidos para cada solicitante.
Microbiologia Clínica Hospitalar
O Laboratório Militello
possui uma unidade técnica que realiza exames microbiológicos, atendendo à pacientes internados que necessitam de resultados precisos e imediatos.
Cotamos com uma equipe altamente especializada, e fornecemos um banco de dados direcionado para cada equipe médica.
Fornecemos aos médicos responsáveis, o Relatório de Infecção Hospitalar, contendo os resultados de pacientes com culturas positivas e respectivos antibióticos liberados.
Além dos exames de microbiologia, realizamos exames de Análises Clínicas e Toxicológicos, de urgência.
Microbiologia - Laboratório de Apoio
Realizamos exames de microbiologia para outros Laboratórios, Clínicas, Hospitais, etc, tendo como diferencial a liberação de resultados parciais e na urgência.
SCIH - SERVIÇO DE INFECÇÃO HOSPITALAR
ANÁLISES CLÍNICAS E TOXICOLÓGICAS
O Laboratório Militello
realiza exames de Análises Clínicas e Toxicológicas
em nossas unidades.
Realizamos exames como Laboratório de Apoio, exames para Clínicas de Repouso e Particulares.
Temos credenciamento com a grande maioria dos convênios médicos e também temos uma TABELA PARTICULAR COM DESCONTOS, e pagamentos facilitados.
Contate-nos
Telefones: 2501-80713208-22442307-9979
Rua Galvão Bueno, 396/412Liberdade, 01506-000São Paulo - SP
contato@militello.com.br
contato@militello.com.br